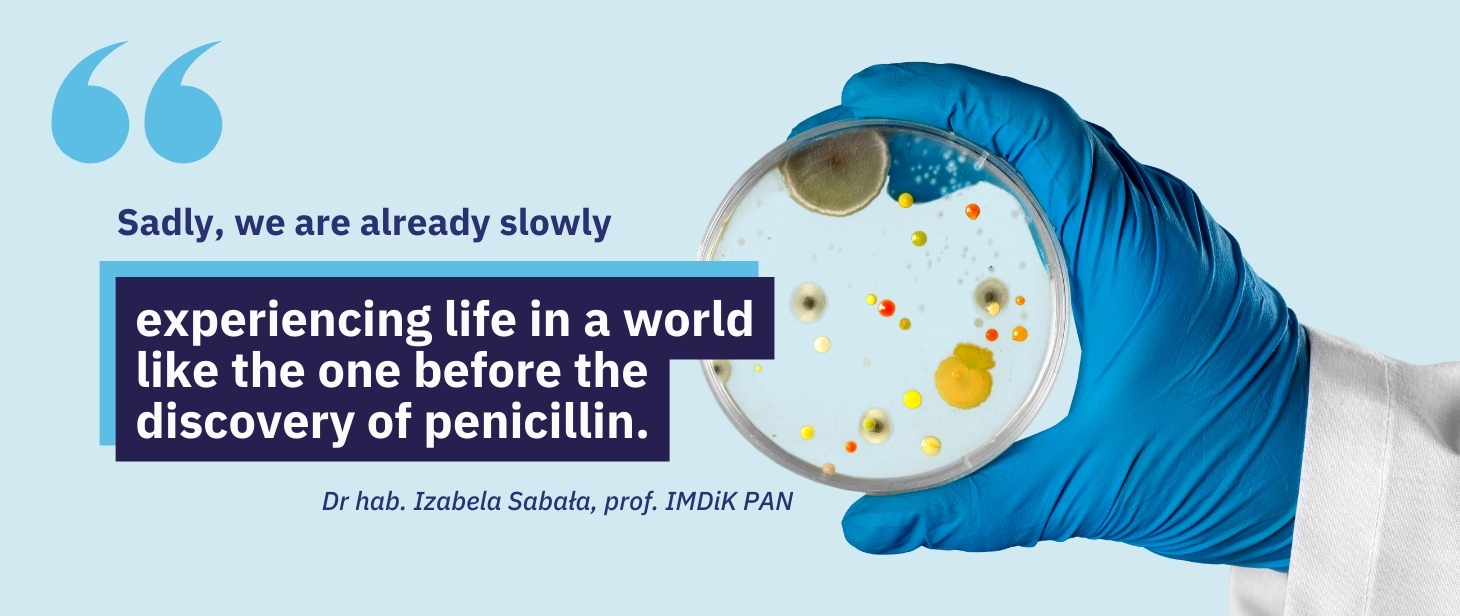

Polish-Norwegian health-oriented cooperation. The story of a project
09.12.2024
Development of an alternative technology related to antibiotics that can significantly contribute to solving the antibiotic resistance crisis. Interesting results, some of which are already in print. Two patent applications and doctoral thesis material. Continuation of cooperation with partners in Norway. Specific plans for the future. These are the direct outcomes of only one of the projects submitted to the National Centre for Research and Development (NCBR) under the ‘Applied research’ Programme. The project was implemented under the Norway Grants. Although the COVID-19 pandemic tried to thwart these plans, the innovators rose to the challenge and brought their work to completion. Be sure to read this story.

Contact with the people responsible for innovative projects is invaluable. It shows the path they have travelled so far. It reveals their passions and dreams. To the category of dreamers, one can definitely include dr hab. Izabela Sabała, professor at the Mossakowski Medical Research Institute, Polish Academy of Sciences (IMDiK PAN).
The person setting the tone for this story has a degree in biology from the University of Lodz and completed doctoral studies at the Swedish University of Agricultural Sciences in Uppsala. She has always been interested in nature.
- It all started with observations and constant "why?" questions. My favourite subject at school was biology, obviously, I focused on biochemistry and physiology while at university, and during my doctoral studies - on proteins. Now, I am involved in in-depth research on one of the groups of proteins, specifically enzymes with antibacterial properties. Thus, I have gone through a kind of evolution of interests, moving from the general to the specifics - says prof. Izabela Sabała.
One thing has not changed. She still asks "why?" questions and tries to find answers to them. She considers inquisitiveness and perseverance to be the most important qualities of her character because, as she points out, without them it is difficult to realise dreams, especially scientific ones. What she values most in her work is combining basic and applied research.
- On the one hand, we study proteins, discover their structure, their way of working and the roles of individual atoms. It is fascinating to try to understand how these miniature machines perform their sometimes very complex tasks. On the other hand, we are investigating the ways of using proteins, or enzymes in our case. Sometimes it is necessary to adjust the properties of enzymes so that they work under certain conditions. We manage to do so precisely because we have learned the basics of their functioning - she explains.
Two lungs of innovation
Today, great emphasis is placed on innovation and applied research, even questioning the wisdom of conducting basic research to expand knowledge or understand certain aspects of phenomena. This is a wrong approach. The projects in which prof. Izabela Sabała and her team are involved prove that the two strands of research are directly connected and that such a combination can bring positive results. And if foreign partners can be involved in the work on the ideas, the chance of success increases.
The PrevEco project completed this year, submitted to the NCBR under the POLNOR 2019 Call for joint Polish-Norwegian research projects, is an excellent example of the above. The IMDiK PAN worked on it together with two partners from Norway: the Norwegian University of Life Sciences (NMBU) and TINE SA, obtaining nearly PLN 6.6 million in funding under the ‘Applied research’ Programme within the framework of the Norwegian Financial Mechanisms 2014-2021.
The National Centre for Research and Development, a government agency connecting the worlds of science and business, is primarily known for awarding grants for the implementation of innovative projects financed from European Funds.
- A slightly less well-known but growing branch of our activities is the participation in numerous international programmes and initiatives. The purpose of the ‘Applied research’ Programme, which we are implementing in cooperation with the Research Council of Norway, is to raise the quality of applied research in our country through the scientific and research cooperation of Poland and Norway. The PrevEco project perfectly demonstrates how promising such cooperation can be. Perhaps it will become an inspiration for someone else? - notes Agnieszka Ratajczak, the Director of the Department of International Cooperation at NCBR.
There are many ways to find project partners. Although the team of prof. Izabela Sabała cooperates with many researchers from abroad on a daily basis, Norwegian teams were not among them.
- We knew that there were groups in Norway involved in the search for new antibacterial substances, as well as companies dealing with problems of bacterial infections. We contacted several potential partners, e-mailing them a collaboration proposal. The response was very positive and exceeded our expectations. We ended up forming two consortia, submitting two proposals and receiving two grants. I led one of them, the person in charge of the other one was dr Elżbieta Jagielska. Both projects concerned the development of alternative non-antibiotic ways of combating bacteria - says prof. Izabela Sabała.
Creativity combined with perseverance
The team led by prof. Sabała focused on developing methods to combat bacterial infections using enzybiotics and bacteriocins while trying to reduce the use of antibiotics. The aim of Dr Elżbieta Jagielska's project, under the short name of SafeFoodCtrl, was to investigate the possibility of replacing antibiotics with enzybiotics in Norwegian salmon farming.
There is no guarantee of success. A good idea, a high scientific value of a project and the innovativeness of a prepared solution are not enough. Determination is also important. As already mentioned, perseverance is a key character feature of the IMDiK PAN researcher. She did not even consider backing out when many small issues arose at the initial stage of the project implementation.
- Yes, the beginnings were not easy. It was 2020, the middle of the pandemic, and we were just starting to coordinate two large grants with foreign partners. We had to find a new place for their implementation. This meant changing the grant promoter, organising and equipping the laboratory and hiring new people. And there were the lock-outs, redundancies and shift work to reduce the risk of getting sick. It was a huge challenge for the whole team. Today, I am proud of my colleagues as they performed their tasks brilliantly despite all the adversities. Thanks to their commitment, we managed to get on track and achieve all the assumptions - says prof. Izabela Sabała.
It all started somewhat by accident
When asked why she decided to deal specifically with antibiotic resistance in bacteria, the PrevEco project investigator explained that it was an important and motivating issue for her and the whole team. However, the work on enzybiotics, i.e. enzymes that destroy bacteria by digesting their cell walls, started many years ago and actually by coincidence. It was preceded by basic research on the structure of one of the proteins found in Staphylococcus aureus.
- We achieved our goal and, in the process, discovered that a fragment of that protein had antibacterial properties. This is how our adventure with enzybiotics began. The PrevEco project is part of that journey - says prof. Izabela Sabała. - The POLNOR Call announced by the NCBR was a perfect fit for our project. We already had pre-developed enzybiotics against staphylococci. We also knew how to create new ones that worked against other harmful bacteria. However, the most important thing for us was to see how it worked in practice. We wanted to transform our theoretical knowledge into something useful and needed - adds the professor.
One of the biggest problems with antibiotics is their overuse and misuse. This leads to the development of bacteria resistance. Few people know that more than 70% of all antibiotics are used in agriculture. This is also one of the reasons for the development of resistance.
- The idea for the PrevEco project came from that knowledge and experience. We wanted to investigate whether enzybiotics and bacteriocins could be used to fight infections in animals. We focused mainly on mastitis, i.e. udder infection in dairy cows. This is a huge problem in the field of agriculture all over the world - points out the researcher.
New antibacterial agents - a natural weapon
The project summary states that if the problem of antibiotic resistance is not solved, we will go back to the days before penicillin. What would the world look like if that happened?
- Sadly, we are already slowly experiencing life in a world like the one before the discovery of penicillin. More and more dangerous bacteria are no longer responding to the available antibiotics - points out prof. Sabała. - In such cases, doctors have nothing to treat patients with. This was the case before the discovery of penicillin.
The number of deaths caused by antibiotic resistance is already of great concern. According to the WHO forecasts, there could be as many as 10 million deaths per year by 2050. This is the scenario if new effective ways to fight bacteria are not developed. Under the OneHealth initiative, the WHO emphasises that the problem of the spread of resistance can only be solved by global actions. The health of people, the environment and animals must be taken care of simultaneously.
Researchers from Poland and Norway want to show that it is not too late to act. They are working on new drugs that will be effective against antibiotic-resistant strains of bacteria. These new agents will not lead to the development of resistance, as is the case with traditional antibiotics.
As part of the PrevEco project, a strategy is proposed to prevent and treat bacterial infections. It is based on enzybiotics. These are enzymes that digest bacterial cell walls, leading to their destruction and death. The Norwegian partners are working on using bacteriocins for that purpose. These are peptides produced by bacteria that eliminate other bacteria in the same niche. Prof. Sabala explains that this is a natural weapon that bacteria use to fight competition. Both methods use substances of natural origin.
- Our approach has a unique feature. It is the selectivity of the action of enzybiotics. They can only destroy specific, pathogenic bacteria. While doing so, they do not affect the natural microflora. This distinguishes our approach from antibiotic therapy. A natural, balanced microbiota is very important for the health of humans and animals - emphasises prof. Izabela Sabała.
Promising test results
The purpose of the project was to develop non-antibiotic ways of preventing and treating bacterial infections. This would help reduce the use of antibiotics in agriculture. The researchers believe that, over time, such an approach could also prove helpful in medicine, having the effect of reducing antibiotic resistance. The results of the research are promising. What has been achieved so far?
- We have developed new enzymes and bacteriocins that act on the bacteria responsible for mastitis in dairy cows and wound infections. We have investigated their way of working and developed production methods. We have tested these substances in laboratories - first in vitro, and then on animal models. We have created initial versions of antibacterial products for udder hygiene. The effectiveness has been confirmed in field tests. We have also investigated how selective removal of harmful bacteria affects the microbiota - lists the project investigator. - The results are optimistic.
Prof. Sabala says that when her team discovered their first antibacterial enzymes, a lot of effort had to be put into adapting their properties to the specific conditions of use. - Under the PrevEco project, we proved that we can reverse that scenario. This means that at the beginning it should be assumed what enzymes are needed for a given application and what properties they must have - then, using the experience, such enzymes should be developed very quickly. It's like sewing tailor-made enzymes - explains the professor.
Another success was the confirmation of positive results in field tests. This is what applied research projects are all about.
- We assumed that the use of enzybiotics in combination with bacteriocins would prevent and treat bacterial infections in animals and that our substances would be effective in removing harmful bacteria and safe for the microbiota. At the same time, we wanted to ensure that their use would not trigger the development of resistance and would be safe for animals and the environment. The research shows that we have achieved that. In future, this should translate into improved animal welfare, reduced use of antibiotics and reduced losses due to mastitis - concludes the professor.
Together we can do more - cooperation under the project
During the first year of the project, each partner had separate tasks. The IMDiK PAN worked on new bacteriolytic enzymes, the NMBU team researched bacteriocins, and TINE conducted talks with milk producers and collected information from them.
Later, the cooperation was strengthened. - We studied how different substances could work together. We tested them in vitro and on animal models. Both teams analysed samples from field tests. This gave us a clear picture of how our antibacterial substances worked and how their use affected the body, especially the microbiota. The common goal helped us to combine our knowledge and experience. This led to efficient work and results that neither partner could have achieved on their own - explains prof. Izabela Sabała.
The cooperation between Polish and Norwegian partners has been successful from the very beginning. The project participants from both countries confirm that nothing has changed in this respect.
- The administrative part proved to be the major challenge. We had to understand each other better. The differences resulted from various experiences and working conditions of scientists in Poland and Norway. For example, I asked for a budget breakdown for the grant application. The answer consisted of only three lines. Remuneration: amount X, reagents: amount Y, travel costs: amount Z. What was missing was a more detailed description and justification of the planned expenses. Together, we managed to adapt that budget to the NCBR requirements. The first version of the substantive report was also very terse. It was only a few statements that everything was going on according to the plan. In the end, also that part of the documentation got the form as the one required from us - points out the project investigator.
The Norwegian partners are satisfied with the quality of joint activities and communication under the project.
- During the project implementation, the cooperation with the laboratory of prof. Izabela Sabała and the NCBR was friendly and fruitful. By combining our knowledge, we discovered a unique combination of antibacterial substances. This helps fight udder infections in cattle. Our cooperation continues. Presently, we are looking for sources of funding to continue the work on the developed agents - says prof. Morten Kjos from the NMBU University. The university is known for its innovative research in the field of sustainable agriculture, inter alia. - The PrevEco project also expanded the network of contacts useful for researchers and students. All participants gained valuable experience in an international collaborative research project - adds the professor.
Håvard Nørstebø, the head of R&D Department at TINE SA, praises the cooperation with the Polish partner. - The project management was professional. Our Polish colleagues were very knowledgeable and showed commitment. This significantly increased the quality of our work. I would also like to thank the National Research and Development Centre for the assistance - says Håvard Nørstebø.
TINE SA is the largest player in the Norwegian dairy products market. The company's mission is to provide consumers with healthy food. The involvement in the PrevEco project is another step in achieving that goal.
The members of the research consortium regularly exchanged e-mails and talked online. Due to the pandemic, the first face-to-face meeting did not take place until halfway through the project. In total, there were three meetings in person: two in Poland and one in Norway. The participants agree that these were much-needed meetings.
Who will benefit from the project results?
Working in consortia is a great way for innovators to gain new knowledge and better understand problems. It makes it possible to obtain results to enable a more complex grasp of the issues under study. It also translates into valuable publications, the building of an international reputation and, often - lifelong friendships.
The project contractors are already reaping many benefits. They have collected interesting results. Some of them have been published and others are on their way to publication. They have filed two patent applications and collected some doctoral thesis material. They are analysing the results together and planning further collaboration. They have many new ideas for the future.
- I value our cooperation and the prospects for its continuation to develop new methods to combat bacteria. Through our research, we would like to contribute to reducing antibiotic resistance, improving the quality of food and lowering the cost of is production. I have no doubt that these developments will be beneficial to everyone. A lot of effort and further investment is still needed to bring our technology into market. However, we believe that this dream will come true - concludes prof. Izabela Sabała.
The EEA and Norway Grants have been enabling the development of international cooperation in the field of science for years. The NCBR programme aims to increase the quality of applied research in our country by strengthening scientific and research cooperation between Poland and Norway, based on the partnership of research organisations and enterprises from both countries.
So far, support has been provided to 1,649 scientists who, thanks to the programme, were able to develop their research in areas such as health, digitalisation, climate and energy. 139 institutions have gained access to funding and opportunities for international collaboration. 81 projects were successful. This has also resulted in 710 peer-reviewed scientific publications, including 189 joint Polish-Norwegian papers.
The current perspective ends in April 2025. The decisions on a new programme financed from the EEA and Norway grants should be made soon.
More information at: gov.pl/ncbr
Do you want to be up to date with the NCBR's offer for innovators?
Subscribe to our newsletter. Sign up